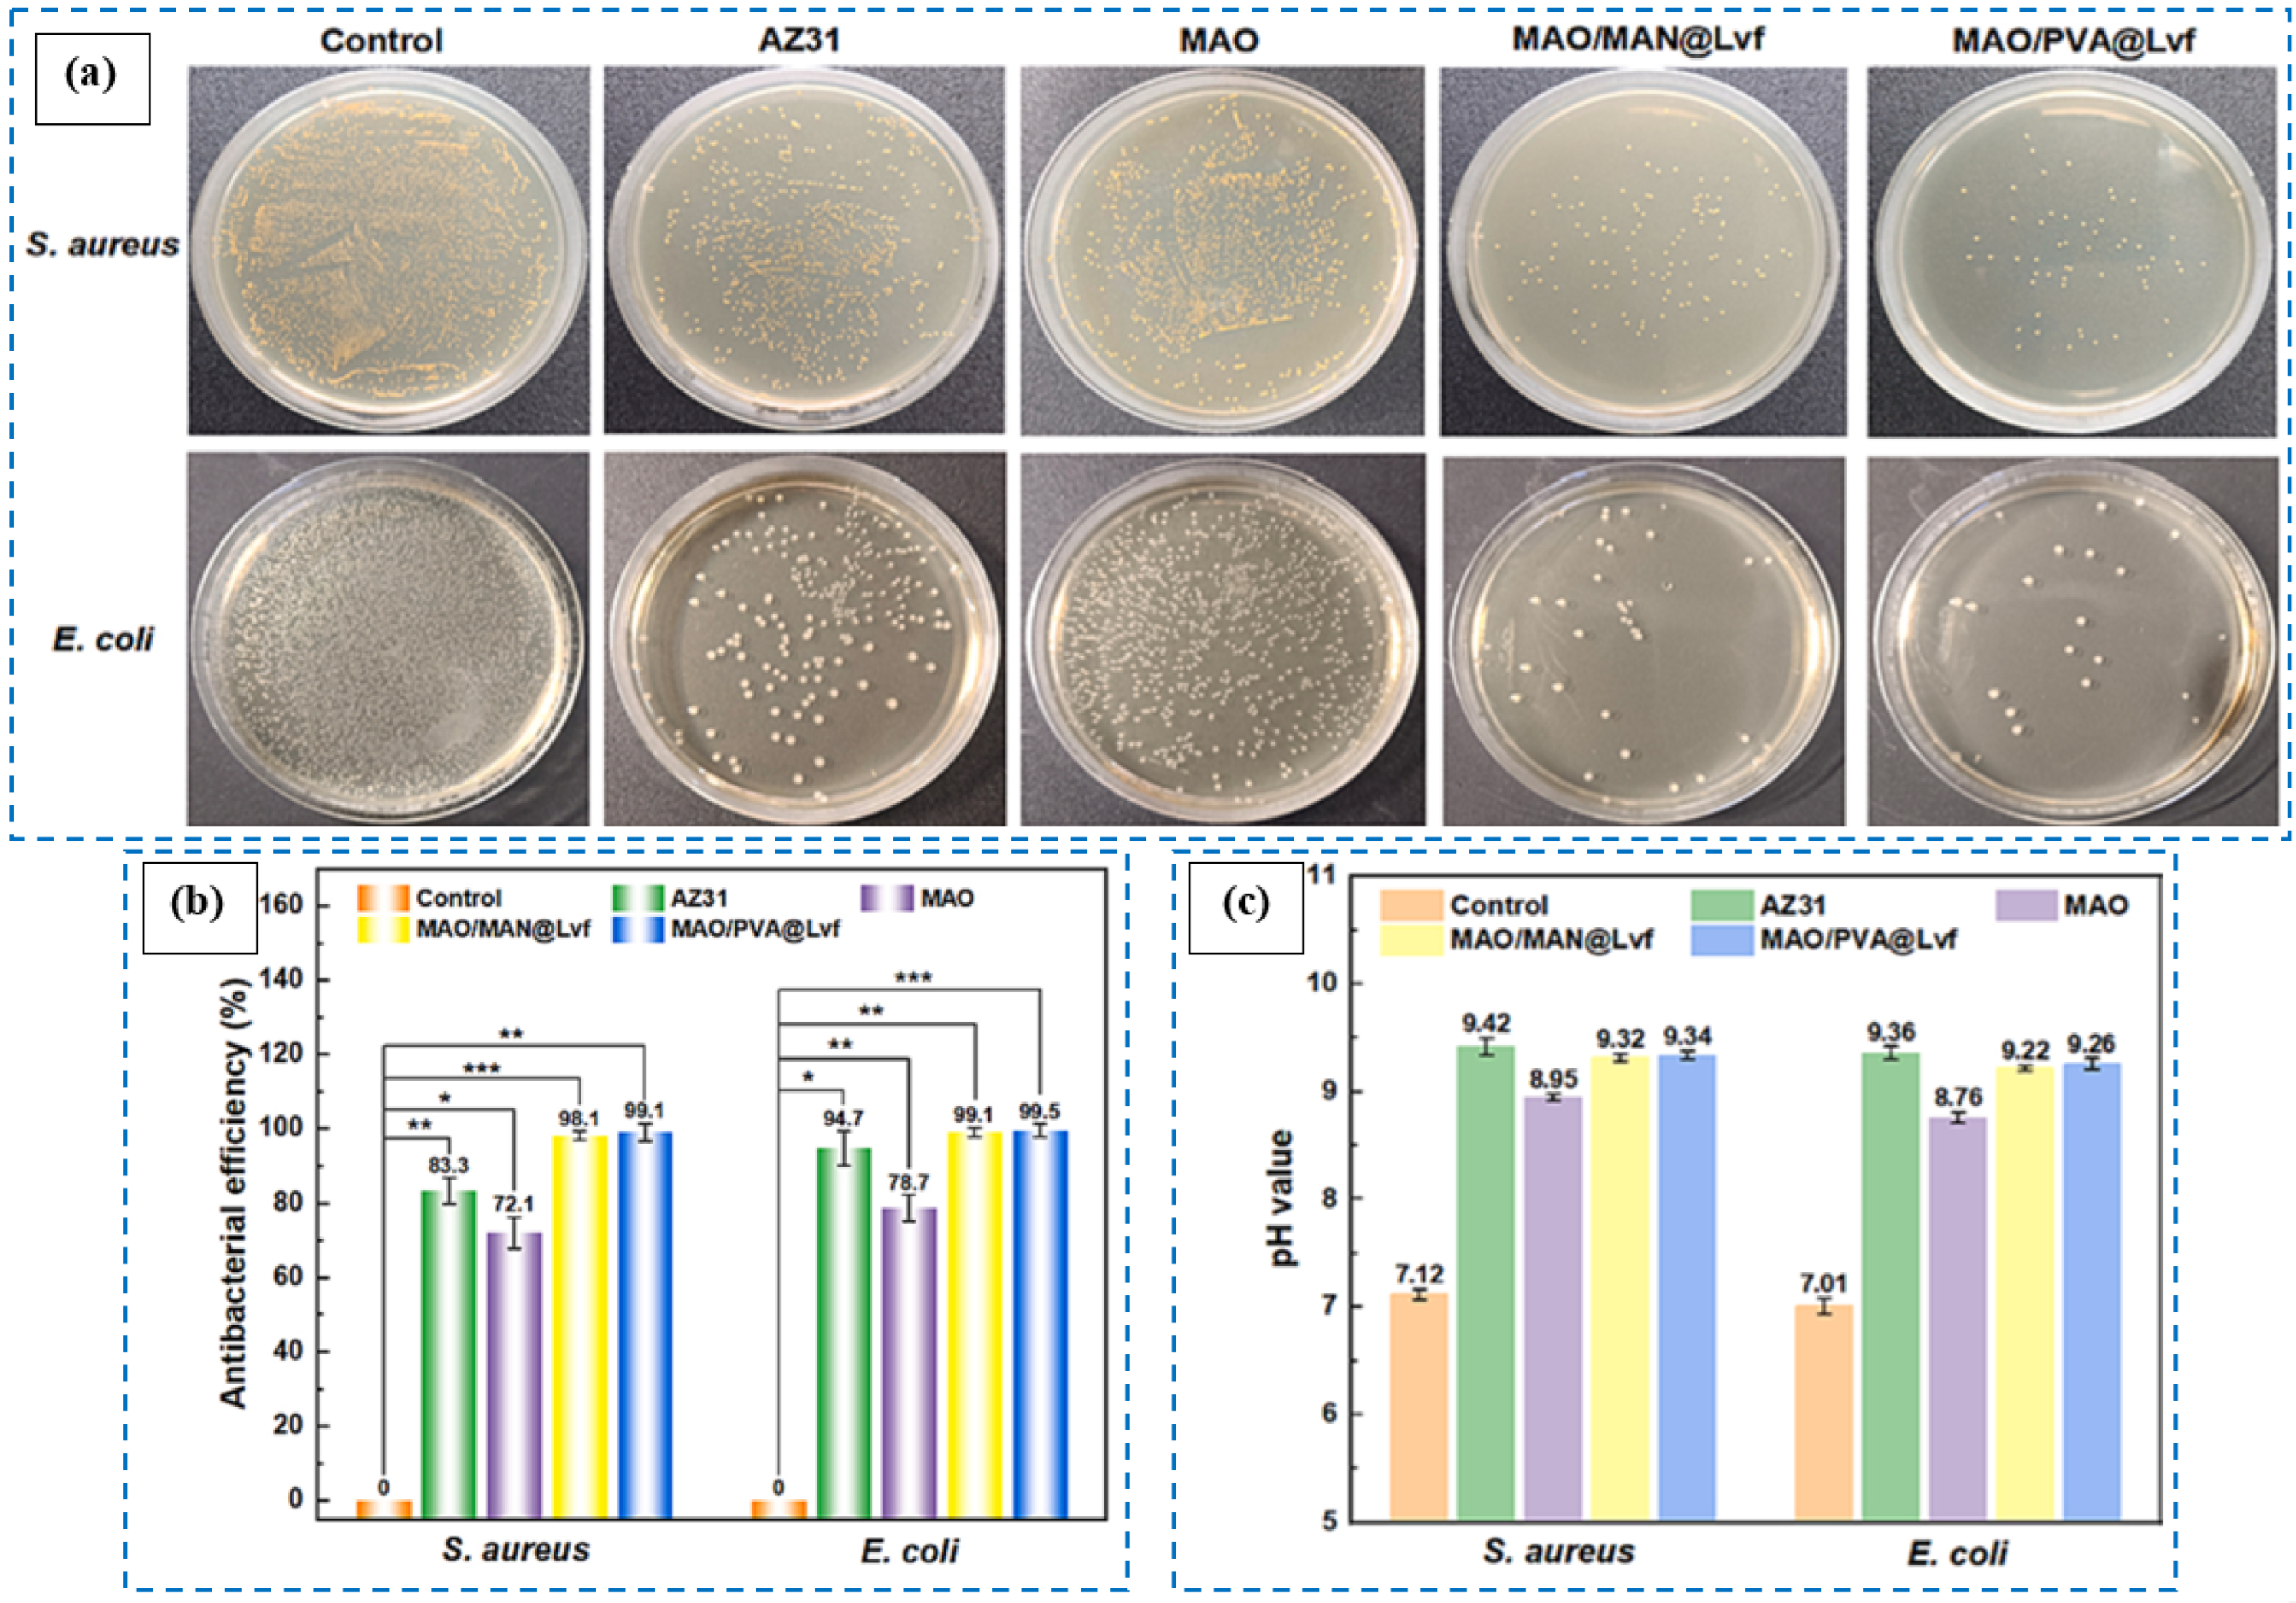
Coatings 15 00925 g006 Coatings 15 00925 g006

Plasma Electrolytic Oxidation (PEO) Coatings for Biomedical Implants: A Review on Enhancing Antibacterial Efficacy Through Controlled Antibiotic Release
Abstract
1. Introduction
2. Antibacterial Coatings
3. Antibacterial Coatings: Release-Killing Strategies
4. PEO Process
5. Antibacterial PEO Coatings: Strategies, Efficacy, and Applications
6. Antibiotic-Loaded PEO Coatings: Mechanisms and Strategies
6.1. Results
6.1.1. Amoxicillin
6.1.2. Cefazolin
6.1.3. Ciprofloxacin
6.1.4. Doxycycline
6.1.5. Levofloxacin
6.1.6. Rifampicin
6.1.7. Tetracycline
6.1.8. Vancomycin
6.2. Discussion
7. Conclusions and Future Prospects
Author Contributions
Funding
Conflicts of Interest
References
- Chopra, D.; Gulati, K.; Ivanovski, S. Understanding and Optimizing the Antibacterial Functions of Anodized Nano-Engineered Titanium Implants. Acta Biomater. 2021, 127, 80–101. [Google Scholar] [CrossRef]
- Pemmada, R.; Shrivastava, A.; Dash, M.; Cui, K.; Kumar, P.; Ramakrishna, S.; Zhou, Y.; Thomas, V.; Nanda, H.S. Science-Based Strategies of Antibacterial Coatings with Bactericidal Properties for Biomedical and Healthcare Settings. Curr. Opin. Biomed. Eng. 2023, 25, 100442. [Google Scholar] [CrossRef]
- Gimeno, M.; Pinczowski, P.; Pérez, M.; Giorello, A.; Martínez, M.Á.; Santamaría, J.; Arruebo, M.; Luján, L. A Controlled Antibiotic Release System to Prevent Orthopedic-Implant Associated Infections: An in Vitro Study. Eur. J. Pharm. Biopharm. 2015, 96, 264–271. [Google Scholar] [CrossRef] [PubMed]
- Wang, N.; Ma, Y.; Shi, H.; Song, Y.; Guo, S.; Yang, S. Mg-, Zn-, and Fe-Based Alloys With Antibacterial Properties as Orthopedic Implant Materials. Front. Bioeng. Biotechnol. 2022, 10, 888084. [Google Scholar] [CrossRef]
- Sathishkumar, G.; Gopinath, K.; Zhang, K.; Kang, E.T.; Xu, L.; Yu, Y. Recent Progress in Tannic Acid-Driven Antibacterial/Antifouling Surface Coating Strategies. J. Mater. Chem. B 2022, 10, 2296–2315. [Google Scholar] [CrossRef]
- Zhang, T.; Liu, Q.; Meng, F.; Hou, Y.; Leung, M.K.H.; Wen, Y.; Zhang, Q. Recent Advances in Stimuli-Responsive Antibacterial Coatings: Bacteria-Killing and Releasing Mechanism, Design Strategies, and Potential Applications. Prog. Org. Coat. 2024, 186, 107923. [Google Scholar] [CrossRef]
- Ordikhani, F.; Tamjid, E.; Simchi, A. Characterization and Antibacterial Performance of Electrodeposited Chitosan-Vancomycin Composite Coatings for Prevention of Implant-Associated Infections. Mater. Sci. Eng. C 2014, 41, 240–248. [Google Scholar] [CrossRef]
- Wang, H.; Xiong, C.; Yu, Z.; Zhang, J.; Huang, Y.; Zhou, X. Research Progress on Antibacterial Coatings for Preventing Implant-Related Infection in Fractures: A Literature Review. Coatings 2022, 12, 1921. [Google Scholar] [CrossRef]
- Rao, Q.; Weng, L.; Zhang, J.; Liu, D.; Zhang, W.; Chen, S.; Chen, J.; Li, X.; Qiu, H.; Cao, Y.; et al. Research Progress in Superhydrophobic Titanium-Based Implants for Antibacterial Applications. Coatings 2023, 13, 419. [Google Scholar] [CrossRef]
- Wang, M.; Zheng, Y.; Yin, C.; Dai, S.; Fan, X.; Jiang, Y.; Liu, X.; Fang, J.; Yi, B.; Zhou, Q.; et al. Recent Progress in Antibacterial Hydrogel Coatings for Targeting Biofilm to Prevent Orthopedic Implant-Associated Infections. Front. Microbiol. 2023, 14, 1343202. [Google Scholar] [CrossRef]
- Zhang, R.; Han, B.; Liu, X. Functional Surface Coatings on Orthodontic Appliances: Reviews of Friction Reduction, Antibacterial Properties, and Corrosion Resistance. Int. J. Mol. Sci. 2023, 24, 6919. [Google Scholar] [CrossRef]
- Forysenkova, A.A.; Fadeeva, I.V.; Deyneko, D.V.; Gosteva, A.N.; Mamin, G.V.; Shurtakova, D.V.; Davydova, G.A.; Yankova, V.G.; Antoniac, I.V.; Rau, J.V. Polyvinylpyrrolidone—Alginate—Carbonate Hydroxyapatite Porous Composites for Dental Applications. Materials 2023, 16, 4478. [Google Scholar] [CrossRef] [PubMed]
- Escobar, A.; Muzzio, N.; Moya, S.E. Antibacterial Layer-by-Layer Coatings for Medical Implants. Pharmaceutics 2021, 13, 16. [Google Scholar] [CrossRef] [PubMed]
- Romanò, C.L.; Scarponi, S.; Gallazzi, E.; Romanò, D.; Drago, L. Antibacterial Coating of Implants in Orthopaedics and Trauma: A Classification Proposal in an Evolving Panorama. J. Orthop. Surg. Res. 2015, 10, 157. [Google Scholar] [CrossRef] [PubMed]
- Chen, X.; Zhou, J.; Qian, Y.; Zhao, L.Z. Antibacterial Coatings on Orthopedic Implants. Mater. Today Bio 2023, 19, 100586. [Google Scholar] [CrossRef]
- Yang, X.; Yu, Q.; Wang, X.; Gao, W.; Zhou, Y.; Yi, H.; Tang, X.; Zhao, S.; Gao, F.; Tang, X. Progress in the Application of Spray-Type Antibacterial Coatings for Disinfection. Trends Food Sci. Technol. 2023, 135, 131–143. [Google Scholar] [CrossRef]
- Hadzhieva, Z.; Boccaccini, A.R. Recent Developments in Electrophoretic Deposition (EPD) of Antibacterial Coatings for Biomedical Applications—A Review. Curr. Opin. Biomed. Eng. 2022, 21, 100367. [Google Scholar] [CrossRef]
- Zhao, C.; Zhou, L.; Chiao, M.; Yang, W. Antibacterial Hydrogel Coating: Strategies in Surface Chemistry. Adv. Colloid Interface Sci. 2020, 285, 102280. [Google Scholar] [CrossRef]
- Akshaya, S.; Rowlo, P.K.; Dukle, A.; Nathanael, A.J. Antibacterial Coatings for Titanium Implants: Recent Trends and Future Perspectives. Antibiotics 2022, 11, 1719. [Google Scholar] [CrossRef]
- Akay, S.; Yaghmur, A. Recent Advances in Antibacterial Coatings to Combat Orthopedic Implant-Associated Infections. Molecules 2024, 29, 1172. [Google Scholar] [CrossRef]
- Wei, T.; Qu, Y.; Zou, Y.; Zhang, Y.; Yu, Q. Exploration of Smart Antibacterial Coatings for Practical Applications. Curr. Opin. Chem. Eng. 2021, 34, 100727. [Google Scholar] [CrossRef]
- Kayani, Z.N.; Intizar, T.; Riaz, S.; Naseem, S. Antibacterial, Magnetic and Dielectric Properties of Nano-Structured V Doped TiO2 Thin Films Deposited by Dip Coating Technique. Mater. Chem. Phys. 2021, 267, 124659. [Google Scholar] [CrossRef]
- Ali, L.A.; Dikici, B.; Aslan, N.; Yilmazer, Y.; Sen, A.; Yilmazer, H.; Niinomi, M. In-Vitro Corrosion and Surface Properties of PVD-Coated β-Type TNTZ Alloys for Potential Usage as Biomaterials: Investigating the Hardness, Adhesion, and Antibacterial Properties of TiN, ZrN, and CrN Film. Surf. Coat. Technol. 2023, 466, 129624. [Google Scholar] [CrossRef]
- Fattah-alhosseini, A.; Molaei, M.; Attarzadeh, N.; Babaei, K.; Attarzadeh, F. On the Enhanced Antibacterial Activity of Plasma Electrolytic Oxidation (PEO) Coatings That Incorporate Particles: A Review. Ceram. Int. 2020, 46, 20587–20607. [Google Scholar] [CrossRef]
- Nikoomanzari, E.; Fattah-alhosseini, A.; Pajohi Alamoti, M.R.; Keshavarz, M.K. Effect of ZrO2 Nanoparticles Addition to PEO Coatings on Ti–6Al–4V Substrate: Microstructural Analysis, Corrosion Behavior and Antibacterial Effect of Coatings in Hank’s Physiological Solution. Ceram. Int. 2020, 46, 13114–13124. [Google Scholar] [CrossRef]
- Molaei, M.; Fattah-alhosseini, A.; Nouri, M.; Mahmoodi, P.; Navard, S.H.; Nourian, A. Enhancing Cytocompatibility, Antibacterial Activity and Corrosion Resistance of PEO Coatings on Titanium Using Incorporated ZrO2 Nanoparticles. Surf. Interfaces 2022, 30, 101967. [Google Scholar] [CrossRef]
- Fattah-alhosseini, A.; Molaei, M.; Nouri, M.; Babaei, K. Antibacterial Activity of Bioceramic Coatings on Mg and Its Alloys Created by Plasma Electrolytic Oxidation (PEO): A Review. J. Magnes. Alloys 2022, 10, 81–96. [Google Scholar] [CrossRef]
- Mozafarnia, H.; Fattah-Alhosseini, A.; Chaharmahali, R.; Nouri, M.; Keshavarz, M.K.; Kaseem, M. Corrosion, Wear, and Antibacterial Behaviors of Hydroxyapatite/MgO Composite PEO Coatings on AZ31 Mg Alloy by Incorporation of TiO2 Nanoparticles. Coatings 2022, 12, 1967. [Google Scholar] [CrossRef]
- Makurat-Kasprolewicz, B.; Ossowska, A. Recent Advances in Electrochemically Surface Treated Titanium and Its Alloys for Biomedical Applications: A Review of Anodic and Plasma Electrolytic Oxidation Methods. Mater. Today Commun. 2023, 34, 105425. [Google Scholar] [CrossRef]
- Noorbakhsh Nezhad, A.H.; Mohammadi Zahrani, E.; Mousavinasab, S.F.; Alfantazi, A.M. A Comprehensive Review of Additively Manufactured Biomedical Titanium Alloys for Bone Tissue Engineering: Biocorrosion, Biomechanical, and Biological Properties. J. Mater. Res. Technol. 2025, 36, 9113–9157. [Google Scholar] [CrossRef]
- Nikoomanzari, E.; Fattah-alhosseini, A. Maximizing the Potential Applications of Plasma Electrolytic Oxidation Coatings Produced on Mg-Based Alloys in Anti-Corrosion, Antibacterial, and Photocatalytic Targeting through Harnessing the LDH/PEO Dual Structure. J. Magnes. Alloys 2024, 12, 2674–2694. [Google Scholar] [CrossRef]
- Rahmati, M.; Mohammadi Zahrani, E.; Atapour, M.; Noorbakhsh Nezhad, A.H.; Hakimizad, A.; Alfantazi, A.M. In Situ Synthesis and Electrochemical Corrosion Behavior of Plasma Electrolytic Oxidation Coating Containing an Osteoporosis Drug on AZ31 Magnesium Alloy. Mater. Chem. Phys. 2024, 315, 128983. [Google Scholar] [CrossRef]
- Attarzadeh, N.; Ramana, C.V. Plasma Electrolytic Oxidation Ceramic Coatings on Zirconium (Zr) and Zr-Alloys: Part-Ii: Properties and Applications. Coatings 2021, 11, 620. [Google Scholar] [CrossRef]
- Shishir, R.; Nasiruddin, U.; Manojkumar, P.; Ponnilavan, V.; Lokeshkumar, E.; Rama Krishna, L.; Rameshbabu, N. Development of Bioactive Ceramic Composite Coating with Bactericidal Property on Zn–1Mg Alloy by Plasma Electrolytic Oxidation for Temporary Orthopaedic Implant Applications. Ceram. Int. 2024, 50, 15538–15550. [Google Scholar] [CrossRef]
- Chen, Z.; Liu, X.; Cheng, Z.; Tan, X.; Xiang, Y.; Li, J.; Zhang, Y.; Lu, Z.; Kang, E.T.; Xu, L.; et al. Degradation Behavior, Biocompatibility and Antibacterial Activity of Plasma Electrolytic Oxidation Treated Zinc Substrates. Surf. Coat. Technol. 2023, 455, 129234. [Google Scholar] [CrossRef]
- Fattah-alhosseini, A.; Molaei, M.; Kaseem, M. A Review on the Plasma Electrolytic Oxidation (PEO) Process Applied to Copper and Brass. Surf. Interfaces 2024, 46, 104179. [Google Scholar] [CrossRef]
- Atapour, M.; Blawert, C.; Zheludkevich, M.L. The Wear Characteristics of CeO2 Containing Nanocomposite Coating Made by Aluminate-Based PEO on AM 50 Magnesium Alloy. Surf. Coat. Technol. 2019, 357, 626–637. [Google Scholar] [CrossRef]
- Fathyunes, L.; Hosseini, M.; Khalil-Allafi, J. In-Vitro Biocompatibility, Antibacterial Activity, and Corrosion Resistance of HA-TiO2/ZnO Coating Fabricated by Plasma Electrolytic Oxidation on Ti6Al4V. Mater. Today Commun. 2024, 40, 109443. [Google Scholar] [CrossRef]
- Curran, J.A.; Clyne, T.W. Porosity in Plasma Electrolytic Oxide Coatings. Acta Mater. 2006, 54, 1985–1993. [Google Scholar] [CrossRef]
- Dunleavy, C.S.; Golosnoy, I.O.; Curran, J.A.; Clyne, T.W. Characterisation of Discharge Events during Plasma Electrolytic Oxidation. Surf. Coat. Technol. 2009, 203, 3410–3419. [Google Scholar] [CrossRef]
- Rizwan, M.; Alias, R.; Zaidi, U.Z.; Mahmoodian, R.; Hamdi, M. Surface Modification of Valve Metals Using Plasma Electrolytic Oxidation for Antibacterial Applications: A Review. J. Biomed. Mater. Res. Part A 2018, 106, 590–605. [Google Scholar] [CrossRef]
- Molaei, M.; Fattah-alhosseini, A.; Nouri, M.; Nourian, A. Systematic Optimization of Corrosion, Bioactivity, and Biocompatibility Behaviors of Calcium-Phosphate Plasma Electrolytic Oxidation (PEO) Coatings on Titanium Substrates. Ceram. Int. 2022, 48, 6322–6337. [Google Scholar] [CrossRef]
- Pesode, P.; Barve, S. Biocompatibility of Plasma Electrolytic Oxidation Coated Titanium Alloy for Biomedical Applications. Bionanoscience 2025, 15, 232. [Google Scholar] [CrossRef]
- Shi, Y.; Xue, Z.; Li, P.; Yang, S.; Zhang, D.; Zhou, S.; Guan, Z.; Li, Y.; Wang, L.N. Surface Modification on Biodegradable Zinc Alloys. J. Mater. Res. Technol. 2023, 25, 3670–3687. [Google Scholar] [CrossRef]
- Bakhsheshi-Rad, H.R.; Hamzah, E.; Ismail, A.F.; Aziz, M.; Najafinezhad, A.; Daroonparvar, M. Synthesis and In-Vitro Performance of Nanostructured Monticellite Coating on Magnesium Alloy for Biomedical Applications. J. Alloys Compd. 2019, 773, 180–193. [Google Scholar] [CrossRef]
- Chen, H.B.; Cui, L.Y.; Liu, W.N.; Zhang, S.C.; Wang, Y.; Li, S.Q.; Liu, C.B.; Zeng, R.C. In Vitro Degradation, Antibacterial Activity and Drug Release of Levofloxacin-Loaded Coatings on Mg Alloy AZ31: The Effect of Chain Length. Prog. Org. Coat. 2024, 189, 108327. [Google Scholar] [CrossRef]
- Xue, K.; Liang, L.X.; Cheng, S.C.; Liu, H.P.; Cui, L.Y.; Zeng, R.C.; Li, S.Q.; Wang, Z.L. Corrosion Resistance, Antibacterial Activity and Drug Release of Ciprofloxacin-Loaded Micro-Arc Oxidation/Silane Coating on Magnesium Alloy AZ31. Prog. Org. Coat. 2021, 158, 106357. [Google Scholar] [CrossRef]
- Nadaraia, K.V.; Mashtalyar, D.V.; Piatkova, M.A.; Pleshkova, A.I.; Imshinetskiy, I.M.; Gerasimenko, M.S.; Belov, E.A.; Kumeiko, V.V.; Kozyrev, D.N.; Fomenko, K.A.; et al. Antibacterial HA-Coatings on Bioresorbable Mg Alloy. J. Magnes. Alloys 2024, 12, 1965–1985. [Google Scholar] [CrossRef]
- Bigham, A.; Saudi, A.; Rafienia, M.; Rahmati, S.; Bakhtiyari, H.; Salahshouri, F.; Sattary, M.; Hassanzadeh-Tabrizi, S.A. Electrophoretically Deposited Mesoporous Magnesium Silicate with Ordered Nanopores as an Antibiotic-Loaded Coating on Surface-Modified Titanium. Mater. Sci. Eng. C 2019, 96, 765–775. [Google Scholar] [CrossRef]
- Pesode, P.; Barve, S. Surface Modification of Titanium and Titanium Alloy by Plasma Electrolytic Oxidation Process for Biomedical Applications: A Review. Mater. Today Proc. 2021, 46, 594–602. [Google Scholar] [CrossRef]
- Ocampo, R.A.; Galvis, O.; Castaño, J.G.; Robledo, S.; Echeverría, F.; Echeverry-Rendón, M. Functionalization of Modified Titanium by Plasma Electrolytic Oxidation with Antibiotic and Cell Adhesion Promoters to Improve Osseointegration Processes. Surf. Coat. Technol. 2024, 481, 130680. [Google Scholar] [CrossRef]
- Kaseem, M.; Dikici, B. Optimization of Surface Properties of Plasma Electrolytic Oxidation Coating by Organic Additives: A Review. Coatings 2021, 11, 374. [Google Scholar] [CrossRef]
- Thukkaram, M.; Cools, P.; Nikiforov, A.; Rigole, P.; Coenye, T.; Van Der Voort, P.; Du Laing, G.; Vercruysse, C.; Declercq, H.; Morent, R.; et al. Antibacterial Activity of a Porous Silver Doped TiO2 Coating on Titanium Substrates Synthesized by Plasma Electrolytic Oxidation. Appl. Surf. Sci. 2020, 500, 144235. [Google Scholar] [CrossRef]
- Xu, D.; Lu, Z.; Wang, T.; Wang, S.; Jiang, Y.; Xu, Z.; Bi, Z.; Geng, S. Novel Ti-Based Alloys Prepared with Different Heat Treatment Strategies as Antibacterial Biomedical Implants. Mater. Des. 2021, 205, 109756. [Google Scholar] [CrossRef]
- Husak, Y.; Ma, J.; Wala-Kapica, M.; Leśniak, K.; Babilas, D.; Blacha-Grzechnik, A.; Dulski, M.; Gawecki, R.; Matuła, I.; Dercz, G.; et al. Antibacterial Coatings on Magnesium Formed via Plasma Electrolytic Oxidation in CuO Suspension. Mater. Chem. Phys. 2024, 323, 129627. [Google Scholar] [CrossRef]
- Liu, D.; Deng, J.; Liu, Z.; Jin, J.; Bi, Y.; Yang, J.; Zhou, S. Effects of ZnO Nanoparticles Addition to Plasma Electrolytic Oxidation Coatings on Magnesium Alloy: Microstructure, in Vitro Corrosion and Antibacterial Properties. J. Mater. Res. 2022, 37, 2897–2909. [Google Scholar] [CrossRef]
- Ferreres, G.; Ivanova, K.; Ivanov, I.; Tzanov, T. Nanomaterials and Coatings for Managing Antibiotic-Resistant Biofilms. Antibiotics 2023, 12, 310. [Google Scholar] [CrossRef]
- Shabatina, T.I.; Vernaya, O.I.; Melnikov, M.Y. Hybrid Nanosystems of Antibiotics with Metal Nanoparticles—Novel Antibacterial Agents. Molecules 2023, 28, 1603. [Google Scholar] [CrossRef]
- Molaei, M.; Fattah-alhosseini, A.; Nouri, M.; Mahmoodi, P.; Nourian, A. Incorporating TiO2 Nanoparticles to Enhance Corrosion Resistance, Cytocompatibility, and Antibacterial Properties of PEO Ceramic Coatings on Titanium. Ceram. Int. 2022, 48, 21005–21024. [Google Scholar] [CrossRef]
- Olmo, J.A.-D.; Ruiz-Rubio, L.; Pérez-Alvarez, L.; Sáez-Martínez, V.; Vilas-Vilela, J.L. Antibacterial Coatings for Improving the Performance of Biomaterials. Coatings 2020, 10, 139. [Google Scholar] [CrossRef]
- Zhao, L.; Chu, P.K.; Zhang, Y.; Wu, Z. Antibacterial Coatings on Titanium Implants. J. Biomed. Mater. Res. Part B Appl. Biomater. 2009, 91, 470–480. [Google Scholar] [CrossRef] [PubMed]
- Ponomarev, V.A.; Orlov, E.A.; Malikov, N.A.; Tarasov, Y.V.; Sheveyko, A.N.; Permyakova, E.S.; Kuptsov, K.A.; Dyatlov, I.A.; Ignatov, S.G.; Ilnitskaya, A.S.; et al. Ag(Pt) Nanoparticles-Decorated Bioactive yet Antibacterial Ca- and P-Doped TiO2 Coatings Produced by Plasma Electrolytic Oxidation and Ion Implantation. Appl. Surf. Sci. 2020, 516, 146068. [Google Scholar] [CrossRef]
- Li, D.; Wang, D.; He, Y.; Tao, B.; Liu, X.; Yang, Y.; Tan, L.; Zhang, Y.; Hu, J.; Yang, W.; et al. A HAase/NIR Responsive Surface on Titanium Implants for Treating Bacterial Infection and Improving Osseointegration. J. Mater. Sci. Technol. 2023, 143, 93–106. [Google Scholar] [CrossRef]
- Kazek-Kęsik, A.; Nosol, A.; Płonka, J.; Śmiga-Matuszowicz, M.; Student, S.; Brzychczy-Włoch, M.; Krok-Borkowicz, M.; Pamuła, E.; Simka, W. Physico-Chemical and Biological Evaluation of Doxycycline Loaded into Hybrid Oxide-Polymer Layer on Ti–Mo Alloy. Bioact. Mater. 2020, 5, 553–563. [Google Scholar] [CrossRef]
- Leśniak-Ziółkowska, K.; Śmiga-Matuszowicz, M.; Blacha-Grzechnik, A.; Student, S.; Brzychczy-Włoch, M.; Krok-Borkowicz, M.; Pamuła, E.; Simka, W.; Kazek-Kęsik, A. Antibacterial and Cytocompatible Coatings Based on Poly(Adipic Anhydride) for a Ti Alloy Surface. Bioact. Mater. 2020, 5, 709–720. [Google Scholar] [CrossRef]
- Huang, W.; Mei, D.; Zhong, Y.; Li, J.; Zhu, S.; Chen, Y.; Wang, L.; Guan, S. The Enhanced Antibacterial Effect of BNNS_Van@CS/MAO Coating on Mg Alloy for Orthopedic Applications. Colloids Surf. B Biointerfaces 2023, 221, 112971. [Google Scholar] [CrossRef]
- Wu, X.; Wyman, I.; Zhang, G.; Lin, J.; Liu, Z.; Wang, Y.; Hu, H. Preparation of Superamphiphobic Polymer-Based Coatings via Spray- and Dip-Coating Strategies. Prog. Org. Coat. 2016, 90, 463–471. [Google Scholar] [CrossRef]
- Ling, L.; Cai, S.; Li, Q.; Sun, J.; Bao, X.; Xu, G. Recent Advances in Hydrothermal Modification of Calcium Phosphorus Coating on Magnesium Alloy. J. Magnes. Alloys 2022, 10, 62–80. [Google Scholar] [CrossRef]
- Majdi, C.; Meffre, P.; Benfodda, Z. Recent Advances in the Development of Bacterial Response Regulators Inhibitors as Antibacterial and/or Antibiotic Adjuvant Agent: A New Approach to Combat Bacterial Resistance. Bioorg. Chem. 2024, 150, 107606. [Google Scholar] [CrossRef]
- Kaiser, K.G.; Delattre, V.; Frost, V.J.; Buck, G.W.; Phu, J.V.; Fernandez, T.G.; Pavel, I.E. Nanosilver: An Old Antibacterial Agent with Great Promise in the Fight against Antibiotic Resistance. Antibiotics 2023, 12, 1264. [Google Scholar] [CrossRef]
- Aryee, A.A.; Han, R.; Qu, L. Occurrence, Detection and Removal of Amoxicillin in Wastewater: A Review. J. Clean. Prod. 2022, 368, 133140. [Google Scholar] [CrossRef]
- Sodhi, K.K.; Kumar, M.; Singh, D.K. Insight into the Amoxicillin Resistance, Ecotoxicity, and Remediation Strategies. J. Water Process Eng. 2021, 39, 101858. [Google Scholar] [CrossRef]
- Araújo Júnior, A.G.; Costa, M.L.V.A.; Silva, F.R.P.; Arcanjo, D.D.R.; Moura, L.F.A.D.; Oliveira, F.A.A.; Soares, M.J.S.; Quelemes, P.V. Amoxicillin-Resistant Streptococci Carriage in the Mouths of Children: A Systematic Review and Meta-Analysis. Pathogens 2022, 11, 1114. [Google Scholar] [CrossRef]
- Hervin, V.; Roy, V.; Agrofoglio, L.A. Antibiotics and Antibiotic Resistance—Mur Ligases as an Antibacterial Target. Molecules 2023, 28, 8076. [Google Scholar] [CrossRef] [PubMed]
- Dastneshan, A.; Rahiminezhad, S.; Naderi Mezajin, M.; Nouri Jevinani, H.; Akbarzadeh, I.; Abdihaji, M.; Qahremani, R.; Jahanbakhshi, M.; Asghari Lalami, Z.; Heydari, H.; et al. Cefazolin Encapsulated UIO-66-NH2 Nanoparticles Enhance the Antibacterial Activity and Biofilm Inhibition against Drug-Resistant S. Aureus: In Vitro and in Vivo Studies. Chem. Eng. J. 2023, 455, 140544. [Google Scholar] [CrossRef]
- Valiulin, S.V.; Onischuk, A.A.; Baklanov, A.M.; Dubtsov, S.N.; An’kov, S.V.; Shkil, N.N.; Nefedova, E.V.; Plokhotnichenko, M.E.; Tolstikova, T.G.; Dolgov, A.M.; et al. Aerosol Inhalation Delivery of Cefazolin in Mice: Pharmacokinetic Measurements and Antibacterial Effect. Int. J. Pharm. 2021, 607, 121013. [Google Scholar] [CrossRef] [PubMed]
- Munir, M.U.; Ihsan, A.; Javed, I.; Ansari, M.T.; Bajwa, S.Z.; Bukhari, S.N.A.; Ahmed, A.; Malik, M.Z.; Khan, W.S. Controllably Biodegradable Hydroxyapatite Nanostructures for Cefazolin Delivery against Antibacterial Resistance. ACS Omega 2019, 4, 7524–7532. [Google Scholar] [CrossRef]
- Khwaza, V.; Mlala, S.; Aderibigbe, B.A. Advancements in Synthetic Strategies and Biological Effects of Ciprofloxacin Derivatives: A Review. Int. J. Mol. Sci. 2024, 25, 4919. [Google Scholar] [CrossRef]
- Shariati, A.; Noei, M.; Chegini, Z. Bacteriophages: The Promising Therapeutic Approach for Enhancing Ciprofloxacin Efficacy against Bacterial Infection. J. Clin. Lab. Anal. 2023, 37, e24932. [Google Scholar] [CrossRef]
- Sodhi, K.K.; Singh, D.K. Insight into the Fluoroquinolone Resistance, Sources, Ecotoxicity, and Degradation with Special Emphasis on Ciprofloxacin. J. Water Process Eng. 2021, 43, 102218. [Google Scholar] [CrossRef]
- Crapnell, R.D.; Adarakatti, P.S.; Banks, C.E. Electroanalytical Overview: The Measurement of Ciprofloxacin. Sens. Diagn. 2023, 3, 40–58. [Google Scholar] [CrossRef]
- Ghasemi, K.; Ghasemi, K. A Brief Look at Antitumor Effects of Doxycycline in the Treatment of Colorectal Cancer and Combination Therapies. Eur. J. Pharmacol. 2022, 916, 174593. [Google Scholar] [CrossRef] [PubMed]
- Feitosa, R.C.; Ishikawa, E.S.A.; da Silva, M.F.A.; da Silva-Júnior, A.A.; Oliveira-Nascimento, L. Five Decades of Doxycycline: Does Nanotechnology Improve Its Properties? Int. J. Pharm. 2022, 618, 121655. [Google Scholar] [CrossRef]
- Cárdenas Sierra, R.S.; Zúñiga-Benítez, H.; Peñuela, G.A. Elimination of Cephalexin and Doxycycline under Low Frequency Ultrasound. Ultrason. Sonochem. 2021, 79, 105777. [Google Scholar] [CrossRef]
- Aniagor, C.O.; Igwegbe, C.A.; Ighalo, J.O.; Oba, S.N. Adsorption of Doxycycline from Aqueous Media: A Review. J. Mol. Liq. 2021, 334, 116124. [Google Scholar] [CrossRef]
- Rizzo, S.; Gambini, G.; De Vico, U.; Rizzo, C.; Kilian, R. A One-Week Course of Levofloxacin/Dexamethasone Eye Drops: A Review on a New Approach in Managing Patients After Cataract Surgery. Ophthalmol. Ther. 2022, 11, 101–111. [Google Scholar] [CrossRef]
- Sitovs, A.; Sartini, I.; Giorgi, M. Levofloxacin in Veterinary Medicine: A Literature Review. Res. Vet. Sci. 2021, 137, 111–126. [Google Scholar] [CrossRef]
- Assaf, H.F.; Shamroukh, A.A.; Rabie, E.M.; Khodari, M. Green Synthesis of CaO Nanoparticles Conjugated with L-Methionine Polymer Film to Modify Carbon Paste Electrode for the Sensitive Detection of Levofloxacin Antibiotic. Mater. Chem. Phys. 2023, 294, 127054. [Google Scholar] [CrossRef]
- Saya, L.; Malik, V.; Gautam, D.; Gambhir, G.; Balendra; Singh, W.R.; Hooda, S. A Comprehensive Review on Recent Advances toward Sequestration of Levofloxacin Antibiotic from Wastewater. Sci. Total Environ. 2022, 813, 152529. [Google Scholar] [CrossRef]
- Khadka, P.; Dummer, J.; Hill, P.C.; Katare, R.; Das, S.C. A Review of Formulations and Preclinical Studies of Inhaled Rifampicin for Its Clinical Translation. Drug Deliv. Transl. Res. 2023, 13, 1246–1271. [Google Scholar] [CrossRef]
- Lee, C.Y.; Huang, C.H.; Lu, P.L.; Ko, W.C.; Chen, Y.H.; Hsueh, P.R. Role of Rifampin for the Treatment of Bacterial Infections Other than Mycobacteriosis. J. Infect. 2017, 75, 395–408. [Google Scholar] [CrossRef] [PubMed]
- Zhang, Y.; Wang, S.; Liu, M.; Yao, S.; Fang, S.; Cheng, H.; Chen, Q. Adjunctive Rifampin Therapy for Diabetic Foot Osteomyelitis: A Protocol for Systematic Review and Meta-Analysis. Medicine 2020, 99, E20375. [Google Scholar] [CrossRef] [PubMed]
- Li, J.; Qin, Y.; Zhao, C.; Zhang, Z.; Zhou, Z. Tetracycline Antibiotics: Potential Anticancer Drugs. Eur. J. Pharmacol. 2023, 956, 175949. [Google Scholar] [CrossRef] [PubMed]
- Abbasnia, A.; Zarei, A.; Yeganeh, M.; Sobhi, H.R.; Gholami, M.; Esrafili, A. Removal of Tetracycline Antibiotics by Adsorption and Photocatalytic-Degradation Processes in Aqueous Solutions Using Metal Organic Frameworks (MOFs): A Systematic Review. Inorg. Chem. Commun. 2022, 145, 109959. [Google Scholar] [CrossRef]
- Fiaz, A.; Zhu, D.; Sun, J. Environmental Fate of Tetracycline Antibiotics: Degradation Pathway Mechanisms, Challenges, and Perspectives. Environ. Sci. Eur. 2021, 33, 64. [Google Scholar] [CrossRef]
- Rusu, A.; Buta, E.L. The Development of Third-Generation Tetracycline Antibiotics and New Perspectives. Pharmaceutics 2021, 13, 2085. [Google Scholar] [CrossRef]
- Rong, M.; Huang, Y.; Lin, C.; Lai, L.; Wu, Y.; Niu, L. Recent Advances in Optical Sensing for Tetracycline Antibiotics. TrAC Trends Anal. Chem. 2024, 178, 117839. [Google Scholar] [CrossRef]
- Zhang, X.; Cai, T.; Zhang, S.; Hou, J.; Cheng, L.; Chen, W.; Zhang, Q. Contamination Distribution and Non-Biological Removal Pathways of Typical Tetracycline Antibiotics in the Environment: A Review. J. Hazard. Mater. 2024, 463, 132862. [Google Scholar] [CrossRef]
- Cafaro, A.; Stella, M.; Mesini, A.; Castagnola, E.; Cangemi, G.; Mattioli, F.; Baiardi, G. Dose Optimization and Target Attainment of Vancomycin in Children. Clin. Biochem. 2024, 125, 110728. [Google Scholar] [CrossRef]
- Haseeb, A.; Alqurashi, M.K.; Althaqafi, A.S.; Alsharif, J.M.; Faidah, H.S.; Bushyah, M.; Alotaibi, A.F.; Elrggal, M.E.; Mahrous, A.J.; Abuhussain, S.S.A.; et al. A Systematic Review on Clinical Safety and Efficacy of Vancomycin Loading Dose in Critically Ill Patients. Antibiotics 2022, 11, 409. [Google Scholar] [CrossRef]
- Cheng, X.; Ma, J.; Su, J. An Overview of Analytical Methodologies for Determination of Vancomycin in Human Plasma. Molecules 2022, 27, 7319. [Google Scholar] [CrossRef]
- Asia, S.; Ejaz, M.; Syed, M.A.; Jackson, C.R.; Sharif, M.; Faryal, R. Epidemiology of Staphylococcus Aureus Non-Susceptible to Vancomycin in South Asia. Antibiotics 2023, 12, 972. [Google Scholar] [CrossRef]

| Substrate | PEO Process Parameters | PEO Coatings Characteristics | Ref | ||
|---|---|---|---|---|---|
| Pore Diameter (µm) | Thickness (µm) | Roughness (µm) | |||
| AZ31 Mg | Electrolyte: 10 g L−1 NaOH and 8 g L−1 phytic acid, current: 1 A, frequency: 500 Hz, duty cycle: 20%, time: 2.5 min | 0.63 ± 0.19 | 4.37 ± 0.95 | 3.96 ± 0.37 | [46] |
| Mg–Mn–Ce | Electrolyte: 25 g L−1 C3H7CaO6P, 5 g L−1 NaF, and 7 g L−1 Na2SiO3; voltage: 380 V, frequency: 300 Hz, time: 100 s | 73–95 | 3.6 ± 0.3 | [48] | |
| Ti | Electrolyte: β-glycerophosphate disodium and calcium acetate monohydrate, voltage: 420 V, time: 6 min | 0.387 | [63] | ||
| Mg–Zn–Y–Nd–Zr | Electrolyte: 54 g L−1 Na3PO4.12H2O, 2 g L−1 NaOH, and 6 mL L−1 C3H8O3; voltage: 200 V; frequency: 800 Hz; time: 4 min | 1–3 | 0.019 | [66] | |
| AZ31 Mg | Electrolyte: 10 g L−1 NaOH and 8 g L−1 phytic acid, voltage: 220–250 V, current density: 0.008–0.016 A cm−2, duty cycle: 50%, time: 10 min | 0.1–0.3 | 3.67 ± 0.81 | 0.8048 ± 0.008 | [47] |
| Ti–15Mo | Electrolyte: 0.1 M Ca(H2PO2)2, voltage: 300 V, current density: 100 mA cm−2, time: 5 min | 0.5 ± 0.09 | [64] | ||
| Ti–Ta–Zr–Nb | Electrolyte: 0.1 M Ca(H2PO2)2, voltage: 300 V, current density: 150 mA cm−2, time: 5 min | 8.54–11.20 | 1.24 ± 0.35 | [65] | |
| Pure Ti | Electrolyte: 8 g L−1 sodium carbonate and 4 g L−1 potassium hydroxide, current density: 1.5 mA cm−2, time: 10 min | 4 | [49] | ||
| Mg–Ca–Zn | Electrolyte: 10 g L−1 Na2SiO3.9H2O, 8 g L−1 KF.2H2O, and 1 g L−1 KOH; voltage: 350 V; current density: 2 A cm−2; time: 10 min | 12 ± 0.5 | [45] | ||
| Antibiotic | Family | Chemical Formula | Chemical Structure | Molar Mass (g mol−1) |
|---|---|---|---|---|
| Amoxicillin | Aminopenicillin | C16H19N3O5S |  | 365.40 |
| Cefazolin | Cephalosporin | C14H14N8O4S3 |  | 454.50 |
| Ciprofloxacin | Fluoroquinolone | C17H18FN3O3 |  | 331.34 |
| Doxycycline | Tetracycline | C22H24N2O8 |  | 444.44 |
| Levofloxacin | Fluoroquinolone | C18H20FN3O4 |  | 361.37 |
| Rifampicin | Rifamycin | C43H58N4O12 |  | 822.95 |
| Tetracycline | Tetracycline | C22H24N2O8 |  | 444.44 |
| Vancomycin | Glycopeptide | C66H75Cl2N9O24 |  | 1449.27 |
Disclaimer/Publisher’s Note: The statements, opinions and data contained in all publications are solely those of the individual author(s) and contributor(s) and not of MDPI and/or the editor(s). MDPI and/or the editor(s) disclaim responsibility for any injury to people or property resulting from any ideas, methods, instructions or products referred to in the content. |
© 2025 by the authors. Licensee MDPI, Basel, Switzerland. This article is an open access article distributed under the terms and conditions of the Creative Commons Attribution (CC BY) license (https://creativecommons.org/licenses/by/4.0/).
Share and Cite
Molaei, M.; Atapour, M.; Mohammadi Zahrani, E. Plasma Electrolytic Oxidation (PEO) Coatings for Biomedical Implants: A Review on Enhancing Antibacterial Efficacy Through Controlled Antibiotic Release. Coatings 2025, 15, 925. https://doi.org/10.3390/coatings15080925
Molaei M, Atapour M, Mohammadi Zahrani E. Plasma Electrolytic Oxidation (PEO) Coatings for Biomedical Implants: A Review on Enhancing Antibacterial Efficacy Through Controlled Antibiotic Release. Coatings. 2025; 15(8):925. https://doi.org/10.3390/coatings15080925
Chicago/Turabian StyleMolaei, Maryam, Masoud Atapour, and Ehsan Mohammadi Zahrani. 2025. "Plasma Electrolytic Oxidation (PEO) Coatings for Biomedical Implants: A Review on Enhancing Antibacterial Efficacy Through Controlled Antibiotic Release" Coatings 15, no. 8: 925. https://doi.org/10.3390/coatings15080925
APA StyleMolaei, M., Atapour, M., & Mohammadi Zahrani, E. (2025). Plasma Electrolytic Oxidation (PEO) Coatings for Biomedical Implants: A Review on Enhancing Antibacterial Efficacy Through Controlled Antibiotic Release. Coatings, 15(8), 925. https://doi.org/10.3390/coatings15080925






